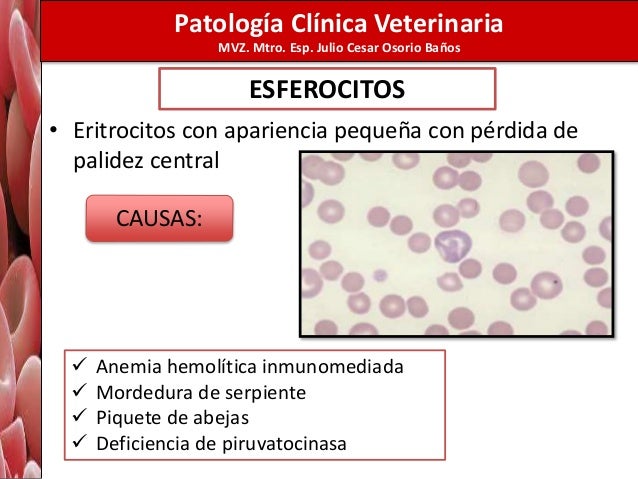

¿Qué significa eritrocitos 0 2 por campo en orina?
La presencia de eritrocitos en la orina es conocida como hematuria, y normalmente está asociada a algún problema a nivel de los riñones, sin embargo, también puede ser consecuencia de la realización de actividad física muy intensa, pese a que es raro, o debido al período menstrual, por ejemplo.
¿Qué significa eritrocitos 2 por campo?
La hematuria o eritrocituria se define como la presencia de hematíes (sangre) en la orina. Aunque la pérdida de sangre a través de la orina en individuos sanos es algo normal, el sangrado debe considerarse patológico cuando el paciente presenta más de 2 hematíes por campo de orina.
¿Cuántos eritrocitos por campo es normal en orina?
Resultados normales Un resultado normal es de 4 glóbulos rojos por campo de gran aumento (GRS/CGA) o menos cuando la muestra se examina bajo un microscopio. El ejemplo anterior es una medición común para un resultado de este examen.
¿Cuántos eritrocitos debe haber por campo?
Resultados normales Los rangos normales de GR son: Hombre: de 4.7 a 6.1 millones de células por microlitro (células/mcL) Mujer: de 4.2 a 5.4 millones de células/mcL.
¿Qué pasa si hay eritrocitos en la orina?
Los glóbulos rojos (eritrocitos) pueden ser un signo de enfermedad renal, trastorno en la sangre u otra enfermedad subyacente, como cáncer de vejiga. Las bacterias, las levaduras o los parásitos pueden indicar una infección. Los cilindros (proteínas con forma de tubo) pueden ser el resultado de trastornos renales.
¿Cuándo preocuparse por sangre en la orina?
Cuándo acudir al médico Cuando se aprecia sangre en la orina se debe consultar con el médico en uno o dos días. Sin embargo, se debe consultar con un médico de inmediato si el sangrado es abundante, si el paciente es incapaz de orinar o si tiene un dolor intenso.
¿Cómo leer un examen de orina para saber si hay infección?
Los pH superiores a 7 pueden sugerir la presencia de bacterias, que alcalinizan la orina, mientras que pH inferiores a 5.5 pueden indicar un estado acidótico en la sangre o enfermedad de los túbulos renales.
¿Cómo saber si está bien un examen de orina?
Un análisis de orina consiste en chequear:Su color.Su aspecto (si es clara o turbia)Su olor.El nivel de acidez (pH)Si hay sustancias que normalmente no están en la orina, como la sangre, el exceso de proteínas, glucosa, cetonas, y bilirrubina.More items...•
¿Qué significa hematíes 1 a 2 por campo?
¿Qué se considera un resultado normal? Un resultado normal es la presencia de hasta 1 o 2 hematíes por campo (High Power Field) al observar una muestra del sedimento urinario al microscopio.
¿Qué significa leucocitos 0 1 en la orina?
La presencia de leucocitos en la orina suele indicar que hay alguna inflamación en la vías urinarias. En general, sugiere infección urinaria, pero puede estar presente en varias otras situaciones, como traumas, uso de sustancias irritantes o cualquier otra inflamación no causada por un agente infeccioso.
¿Qué significa eritrocitos +++?
Los eritrocitos son los hematíes: es decir, los glóbulos rojos. Se trata de células globosas que se encuentran en la sangre. Hay dos tipos de glóbulos: los rojos o hematíes y los blancos, también conocidos como leucocitos. Estas células cumplen con distintas funciones que son importantes para el organismo.
¿Cuáles son los valores normales en un examen de orina?
Valores normales de laboratorio: orinaEstudioMuestraUnidades convencionalesMujeresOrina, 24 h0-100 mg/24 hVaronesOrina, 24 h4–40 mg/24 hCreatinina, basada en el pesoOrina, 24 h15-25 mg/kg/24 hExcreción de d-xilosa 5 h después de la ingestión de 25 g de d-xilosaOrina, recolección de 5 horas5-8 g62 more rows
¿Qué significa hematíes 1 a 2 por campo?
¿Qué se considera un resultado normal? Un resultado normal es la presencia de hasta 1 o 2 hematíes por campo (High Power Field) al observar una muestra del sedimento urinario al microscopio.
¿Qué significa células epiteliales 0 2 por campo?
La presencia de células epiteliales en la orina se considera normal y generalmente no tiene relevancia clínica, ya que indica una descamación natural del tracto urinario que son eliminadas en la orina.
¿Qué significa leucocitos 3 a 5 por campo?
En este caso, los valores normales son descritos de dos formas: Menor de 3 a 5 hematíes por campo o menos de 10.000 células por mL. La presencia de sangre en la orina, se llama de hematuria y puede ocurrir por diversas enfermedades, como infecciones, piedras en los riñones y enfermedades renales graves.
¿Qué significa leucocitos 1 2 en la orina?
La presencia en número elevado de leucocitos o glóbulos blancos en la orina al estudiar al microscopio el sedimento urinario suele ser indicio de una inflamación o infección del tracto urinario.
¿Qué son los eritrocitos?
Un eritrocito sano es una célula nucleada en forma de disco, con sangría hacia adentro. Consiste en el 90 por ciento del pigmento rojo hemoglobina. Los eritrocitos se producen a partir de células madre en la médula ósea con la ayuda de hierro, ácido fólico y vitamina B12. Este proceso está controlado por la hormona eritropoyetina, también conocida como EPO.
¿Cómo se mide el número de eritrocitos?
El número de eritrocitos se mide en sangre completa. Para hacer esto, los eritrocitos primero se cuentan por máquina. Si hay alguna anomalía, también se realiza una evaluación microscópica de la sangre. Además, el hemograma pequeño no solo determina el número de eritrocitos, sino también otras propiedades como la forma, volumen y color de las células sanguíneas y su contenido de hemoglobina con los valores MCH, MCHC y MCV.
¿Qué célula tiene hemoglobina?
Los eritrocitos, como los trombocitos y los leucocitos, pertenecen a las células sanguíneas. Con el pigmento sanguíneo hemoglobina, transportan oxígeno desde los pulmones a través de los vasos sanguíneos más pequeños (capilares) al tejido. La cantidad de eritrocitos en la sangre proporciona información, entre otras cosas, sobre qué tan bien se suministra oxígeno al cuerpo.
¿Qué causa el aumento de glóbulos rojos?
Si aumenta el número de glóbulos rojos, es posible que disminuya el nivel de oxígeno en la sangre. Este es el caso de una enfermedad cardíaca o pulmonar. El recuento de eritrocitos también puede aumentar en fumadores y debido a una pérdida grave de líquidos. La enfermedad renal también hace que el cuerpo tenga demasiados glóbulos rojos. En determinadas enfermedades, se producen demasiados eritrocitos en la médula ósea. Entonces, la sangre es “más espesa” y aumenta el riesgo de trombosis.
1 respuesta
los valores normales en varones es de 1 a 2 por campo; en este caso existe algún lugar por el cual hay pequeñas hemorragias que te dan dichos valores, ahora esto se puede deber desde una lesión en la uretra que es el conducto por donde sale la orina, una lesión de prostata también o algo mayor como problemas renales.
Tu respuesta
Los datos recopilados son enviados a Communitic International para asegurar el buen funcionamiento de la moderación y de las notificaciones en nuestros foros.
¿Qué pasa si tengo los eritrocitos altos en la orina?
A pesar de que frecuentemente se encuentra relacionada con alteraciones en los riñones, es posible también que los eritrocitos altos en la orina aparezcan debido a actividad física excesiva, lo que puede ocurrir como consecuencia de una lesión en la vejiga o deshidratación, por ejemplo; sin embargo, la hematuria debido a ejercicios es inusual.
¿Cómo se pueden detectar los eritrocitos en la orina?
La presencia de eritrocitos en la orina se nota principalmente por medio del color de la misma, que se torna rosada, rojo vivo u oscura, dependiendo de la cantidad de eritrocitos. Asimismo, a partir de la visualización de la orina a través del microscopio, puede ser determinada la presencia de numerosos eritrocitos intactos, además de productos de su degradación, como la hemoglobina, que es identificada por medio de la prueba de la tira reactiva.
¿Qué hacer cuando hay hematuria?
El tratamiento para la hematuria es indicado por el médico, de acuerdo con la causa; es decir, en el caso de que los eritrocitos altos en la orina sean debido a infecciones, el médico puede recomendar el uso de antibióticos para combatir el agente infeccioso y, de esta forma, disminuir la cantidad de eritrocitos presentes.
¿ Porque os eritrócitos é altos?
As principais causas de aumento dos eritrócitos são o tabagismo, a hipoxemia arterial crônica e os tumores.
¿ O que é o glóbulo vermello?
Os eritrócitos (também conhecidos como hemácias ou glóbulos vermelhos) são responsáveis pelo transporte de oxigênio dos pulmões para os tecidos do corpo. A sua coloração vermelha é devida a uma proteína presente no interior dessas células chamada hemoglobina, que se liga ao oxigênio e permite que as hemácias cumpram a sua função.
